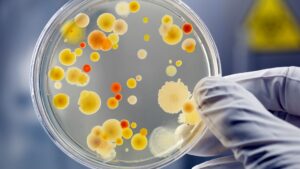
Piyeloseptyl ne ise yarar

Piyeloseptyl ne işe yarar? Ne için kullanılır? Yan etkileri, Piyeloseptyl nedir? Nasıl kullanmalıyım? Ayrıntılı kullanımı, dozu, diğer ilaçlarla etkileşimi,

Piyeloseptyl ne işe yarar? (Piyeloseptil ne işe yarar?)
Türkçe okunuşu ve yazılışı piyeloseptil dir.
Piyeloseptyl idrar yolu enfeksiyonlarını tedavi etmek için kullanılır.
Piyeloseptyl bir antibiyotiktir. Bakterileri öldürerek veya büyümelerini önleyerek çalışır.
Bununla birlikte, Piyeloseptyl soğuk algınlığı, grip veya diğer virüs enfeksiyonları için çalışmaz.
Piyeloseptyl endikasyonları
Endikasyon, ilacın hasta tarafından reçete edildiği veya kullanıldığı durum veya semptom veya hastalık listesi için kullanılan bir terimdir.
Örneğin, hasta tarafından ateş için asetaminofen veya parasetamol kullanılır veya doktor bunu baş ağrısı veya vücut ağrıları için reçete eder.
Şimdi ateş, baş ağrısı ve vücut ağrıları parasetamolün belirtileridir.
Bir hasta, yaygın durumlar için kullanılan ilaçların endikasyonlarının farkında olmalıdır, çünkü bunlar eczanede reçetesiz olarak alınabilir. Ama doktor tavsiyesi olmadan kullanılması önerilmemektedir.
Piyeloseptyl Kapsüller, USP (makro kristaller), duyarlı Escherichia coli, enterokok, Staphylococcus aureus suşları ve bazı duyarlı Klebsiella ve Enterobacter türleri suşları nedeniyle idrar yolu enfeksiyonlarının tedavisi için spesifik olarak endikedir.
Piyeloseptyl, piyelonefrit veya perinefrik apselerin tedavisi için endike değildir.
İlaca dirençli bakterilerin gelişimini azaltmak ve Piyeloseptil Kapsüller, USP (makrokristaller) ve diğer antibakteriyel ilaçların etkinliğini korumak için Piyeloseptil Kapsüller, USP (makrokristaller) yalnızca duyarlı bakterilerin neden olduğu kanıtlanmış veya güçlü bir şekilde şüphelenilen enfeksiyonları tedavi etmek veya önlemek için kullanılmalıdır.
Kültür ve duyarlılık bilgileri mevcut olduğunda, antibakteriyel tedavinin seçiminde veya değiştirilmesinde dikkate alınmalıdır.
Bu tür verilerin yokluğunda, lokal epidemiyoloji ve duyarlılık paternleri ampirik tedavi seçimine katkıda bulunabilir.
Nitrofurantoinler, idrar yolu enfeksiyonları için onaylanmış diğer terapötik ajanların daha geniş doku dağılımından yoksundur.
Sonuç olarak, Piyeloseptyl Kapsüller, USP (makrokristaller) ile tedavi edilen birçok hasta, bakteriürinin kalıcılığına veya yeniden ortaya çıkmasına yatkındır.
Kültür ve duyarlılık testi için idrar örnekleri, tedavinin tamamlanmasından önce ve sonra alınmalıdır.
Piyeloseptyl Kapsüller, USP (makrokristaller) ile tedaviden sonra bakteriürinin kalıcılığı veya yeniden ortaya çıkması meydana gelirse, daha geniş doku dağılımına sahip diğer terapötik ajanlar seçilmelidir.
Piyeloseptyl Kapsüllerin, usp’nin (makrokristaller) kullanımı göz önüne alındığında, daha düşük eradikasyon oranları, daha geniş doku dağılımına sahip ajanlar kullanıldığında artan sistemik toksisite potansiyeline ve antimikrobiyal direnç gelişimine karşı dengelenmelidir.

Piyeloseptyl nasıl kullanılır?
Piyeloseptyl süspansiyonunu doktorunuzun talimatına göre kullanın.
Piyeloseptyl süspansiyonunu yiyecekle birlikte ağızdan alın.
Her kullanımdan önce iyice çalkalayın.
İlaç dozlaması için işaretlenmiş bir ölçüm cihazı kullanın.
Dozunuzu nasıl ölçeceğinizden emin değilseniz eczacınızdan yardım isteyin.
Piyeloseptyl süspansiyonu alırken fazladan sıvı içilmesi önerilir. Talimatlar için doktorunuza danışın.
Piyeloseptyl süspansiyonu alırken içinde magnezyum trisilikat bulunan bir antasit almayın.
Hangi antasitlerin içinde magnezyum trisilikat olduğundan emin değilseniz eczacınıza danışın.
Enfeksiyonunuzu tamamen temizlemek için, tedavinin tamamı boyunca Piyeloseptil süspansiyonu alın.
Birkaç gün içinde daha iyi hissetseniz bile almaya devam edin.
Bir doz Piyeloseptil süspansiyonunu kaçırırsanız, mümkün olan en kısa sürede alın.
Bir sonraki dozunuzun zamanı geldiyse, kaçırılan dozu atlayın ve normal doz programınıza geri dönün.
Aynı anda 2 doz almayın.
Piyeloseptil süspansiyonunun nasıl kullanılacağı hakkında sahip olabileceğiniz soruları sağlık uzmanınıza sorun.
Piyeloseptyl ayrıntılı kullanımı
Bir ilacın veya ilacın spesifik ve genel kullanımları vardır. Bir hastalığı önlemek, bir hastalığı belirli bir süre boyunca tedavi etmek veya bir hastalığı tedavi etmek için bir ilaç kullanılabilir.
Hastalığın belirli semptomunu tedavi etmek için de kullanılabilir. İlaç kullanımı hastanın aldığı forma bağlıdır.
Enjeksiyon formunda veya bazen tablet formunda daha faydalı olabilir.
İlaç, tek bir rahatsız edici semptom veya hayatı tehdit eden bir durum için kullanılabilir.
Bazı ilaçlar birkaç gün sonra durdurulabilirken, bazı ilaçların bundan faydalanabilmesi için uzun süre devam ettirilmesi gerekir.
Bu ilaç bazı idrar yolu enfeksiyonlarını tedavi etmek veya önlemek için kullanılır.
Bu ilaç, bakteri üremesini durdurarak çalışan bir antibiyotiktir.
Viral enfeksiyonlar (örneğin soğuk algınlığı, grip) için işe yaramaz. Herhangi bir antibiyotiğin gereksiz kullanımı veya aşırı kullanımı, etkinliğinin azalmasına neden olabilir.
Piyeloseptil, belirli bir kan sorunu (hemolitik anemi) riski nedeniyle bir aydan küçük çocuklarda kullanılmamalıdır.

Piyeloseptil nasıl kullanılır?
Bu ilacı doktorunuzun önerdiği şekilde ağızdan, yiyecek veya sütle birlikte alın.
Bu ilaç genellikle bir enfeksiyonu tedavi etmek için günde dört kez veya enfeksiyonları önlemek için yatmadan önce günde bir kez alınır.
İlacı tamamen yutun. Bu ilacı kullanırken magnezyum trisilikat içeren antasitler kullanmaktan kaçının.
Magnezyum trisilikat içeren antasitler Piyeloseptil ile bağlanarak tam emilimini engeller.
Dozaj ve süre, tıbbi durumunuza ve tedaviye yanıtınıza bağlıdır. Çocuklar için dozaj ayrıca vücut ağırlığına da dayanır.
Antibiyotikler, vücudunuzdaki ilaç miktarı sabit bir seviyede tutulduğunda en iyi sonucu verir. Bu nedenle, bu ilacı eşit aralıklarla alın.
Enfeksiyonu önlemek için bu ilacı kullanırken, tam olarak doktorunuzun önerdiği şekilde alın. Dozları atlamayın veya doktorunuzun onayı olmadan almayı bırakmayın.
Yeni bir idrar yolu enfeksiyonu belirtileri fark ederseniz (örneğin idrar yaparken ağrı) doktorunuzu bilgilendirin.
Bir enfeksiyonu tedavi etmek için bu ilacı kullanıyorsanız, semptomlar birkaç gün sonra kaybolsa bile, tam reçete edilen miktar bitene kadar bu ilacı almaya devam edin.
İlacın çok erken kesilmesi bakterilerin büyümeye devam etmesine izin verebilir ve bu da enfeksiyonun nüksetmesine neden olabilir. Durumunuz devam ederse veya kötüleşirse doktorunuzu bilgilendirin.
Piyeloseptyl nedir?
Enfekte organizmanın konsantrasyonuna ve duyarlılığına bağlı olarak bakteriyostatik veya bakterisidal bir ajan. Piyeloseptil, S. aureus, S. epidermidis, S. saprophyticus, Enterococcus faecalis, S. agalactiae, D grubu streptokoklar, viridians streptokoklar ve Corynebacterium gibi bazı gram pozitif organizmalara karşı aktiftir.
Negatif organizmalara karşı aktivite spektrumu şunları içerir: E. coli, Enterobacter, Neisseria, Salmonella ve Shigella.
İdrar yolu enfeksiyonlarını tedavi etmek için trimetoprim / sülfametoksazole alternatif olarak kullanılabilir, ancak vajinal bakterileri yok etmede daha az etkili olabilir.
Kadınlarda cinsel ilişkiye bağlı tekrarlayan sistite karşı profilaksi olarak da kullanılabilir.
Piyeloseptyl, etki mekanizmalarının çokluğundan kaynaklandığı düşünülen bir özellik olan bakteri direncinin gelişimine karşı oldukça kararlıdır.

Piyeloseptyl dozu
Genel adı
Piyeloseptyl 5ml’de 25mg
Dozaj formu
Oral süspansiyon
Piyeloseptyl, ilaç emilimini ve bazı hastalarda toleransı iyileştirmek için gıda ile birlikte verilmelidir.
Yetişkinler
Günde dört kez 50-100 mg – komplike olmayan idrar yolu enfeksiyonları için daha düşük dozaj seviyesi önerilir.
Pediatrik Hastalar
24 saatte 5-7 mg / kg vücut ağırlığı, dört bölünmüş dozda verilir (bir ayın altında kontrendikedir).
Aşağıdaki tablo, dört bölünmüş dozda verilen 24 saatte 5 ila 6 mg / kg vücut ağırlığı alan her aralıktaki ortalama ağırlığa dayanmaktadır.
Ortalama bir piyeloseptyl dozunu hesaplamak için kullanılabilir
Pediatrik hastalar için oral Süspansiyon (25 mg / 5 ml).
Yetişkinlerde uzun süreli baskılayıcı tedavi için, yatmadan önce dozajın 50-100 mg’a düşürülmesi yeterli olabilir.
Pediatrik hastalarda uzun süreli baskılayıcı tedavi için, tek bir dozda veya iki bölünmüş dozda verilen 24 saatte 1 mg / kg kadar düşük dozlar yeterli olabilir.
Piyeloseptyl etkileşimleri
Piyeloseptyl ile etkileşen diğer ilaçlar hangileridir?
Gastrointestinal advers reaksiyonlar, ilacı süt veya yiyecekle birlikte alarak veya dozajın azaltılmasıyla en aza indirilebilir.
Gastrointestinal advers reaksiyonlar, ilacı süt veya yiyecekle birlikte alarak veya dozajın azaltılmasıyla en aza indirilebilir.

Piyeloseptyl ilaç etkileşimleri
Magnezyum trisilikat içeren antasitler, Piyeloseptil makrokristallerle (Piyeloseptil) birlikte uygulandığında emilim derecesini azaltır.
Probenesid ve sülfinpirazon gibi ürikosürik ilaçlar, Piyeloseptilin renal tübüler sekresyonunu inhibe edebilir.
Piyeloseptil serum seviyelerinde ortaya çıkan artış toksisiteyi artırabilir ve azalan idrar seviyeleri etkinliğini azaltabilir.
Kinolonların birlikte uygulanması önerilmez.
Piyeloseptil makrokristallerin (Piyeloseptil) antibakteriyel aktivitesi, karbonik anhidraz inhibitörleri ve idrar alkalileştirici ajanların varlığında azalabilir.
Laboratuvar testleri ile
Piyeloseptil, bilirubin, kan üre azotu, protein olmayan azot, kreatin ve kreatinin, glikoz (Benedict çözeltisi), alkalin fosfataz, kolesterol, timole berraklık, SGOT, SGPT, azalmış hemoglobin, artmış serum fosforunun belirlenmesinde yanlış pozitif reaksiyona veya artmış değerlere neden olabilir.
Piyeloseptyl yan etkileri nelerdir?
Solunum
Kronik , subakut veya akut pulmoner hipersensiticite reaksiyonları meydana gelebilir.
Kronik pulmoner reaksiyonlar genellikle altı ay veya daha uzun süre sürekli tedavi gören hastalarda ortaya çıkabilir.
Halsizlik , eforda nefes darlığı, öksürük ve değişen solunum fonsiyonu sinsice ortaya çıkabilen yaygın belirtilerdir.
Subakut pulmoner reaksiyonlarda ateş ve eozinofili akut formdan daha az görülür.
Tedavinin kesilmesi üzerine iyileşme birkaç ay sürebilir. Semptomlar ilaca bağlı olarak tanınmazsa ve Piyeloseptil tedavisi durdurulmazsa semptomlar daha şiddetli hale gelebilir.
Akut pulmoner reaksiyonlar genellikle ateş, titreme, öksürük, göğüs ağrısı, nefes darlığı, röntgende plevral efüzyonun konsolidasyonu ile pulmoner infiltrasyon ve eozinofili ile kendini gösterir.
Akut reaksiyonlar genellikle tedavinin ilk haftasında ortaya çıkar ve tedavinin kesilmesiyle geri dönüşümlüdür. Çözünürlük genellikle dramatiktir.
Pulmoner reaksiyonlarla ilişkili olarak ekg’deki değişiklikler (örneğin, spesifik olmayan ST / T dalgası değişiklikleri, dal bloğu) bildirilmiştir. Siyanoz nadiren bildirilmiştir.
Hepatik
Hepatit, kolestatik sarılık, kronik aktif hepatit ve hepatik nevroz dahil hepatik reaksiyonlar nadiren görülür.
Nörolojik
Şiddetli veya geri dönüşü olmayan periferik nöropati meydana gelmiştir.
Böbrek yetmezliği (dakikada 60 ml’nin altında kreatinin klirensi veya klinik olarak anlamlı yüksek serum kreatinin), anemi, diabetes mellitus, elektrolit dengesizliği, B vitamini eksikliği ve zayıflatıcı hastalıklar gibi durumlar periferik nöropati olasılığını artırabilir
Piyeloseptil kullanımı ile asteni, baş dönmesi, nistagmus, baş dönmesi, baş ağrısı ve uyuşukluk da bildirilmiştir.
Nadiren benign intrakraniyal hipertansiyon (psödotümör serebri), konfüzyon, depresyon, optik nörit ve psikotik reaksiyonlar bildirilmiştir.
Bebeklerde iyi huylu intrakraniyal hipertansiyonun bir işareti olarak şişkin fontaneller nadiren bildirilmiştir.
Dermatolojik
Eksfolyatif dermatit ve eritema multiforme (Stevens-Johnson sendromu dahil) nadiren bildirilmiştir. Geçici alopesi de bildirilmiştir.
Alerjik
Piyeloseptile pulmoner reaksiyonlarla ilişkili lupus benzeri bir sendrom bildirilmiştir.
Ayrıca anjiyoödem; makülopapüler, eritemli veya ekzematöz erüpsiyonlar; kaşıntı; ürtiker; anafilaksi; artralji; miyalji; ilaç ateşi; ve vaskülit (bazen pulmoner reaksiyonlarla ilişkili) bildirilmiştir.
Aşırı duyarlılık reaksiyonları, Piyeloseptil formülasyonları ile dünya çapında pazarlama sonrası deneyimde kendiliğinden bildirilen en sık görülen advers olayları sunar.
Gastrointestinal
Bulantı, kusma ve anoreksi en sık görülür. Karın ağrısı ve ishal daha az görülen gastrointestinal reaksiyonlardır. Doza bağlı bu reaksiyonlar, dozaj azaltılarak en aza indirilebilir. Sialadenit ve pankreatit bildirilmiştir.
Piyeloseptil kullanımı ile sporadik psödomembranöz kolit raporları olmuştur. Psödomembranöz kolit semptomlarının başlangıcı antimikrobiyal tedavi sırasında veya sonrasında ortaya çıkabilir.
Hematolojik
Nadiren methemoglobinemiye sekonder siyanoz bildirilmiştir.
Çeşitli yan etkiler
Diğer antimikrobiyal ajanlarda olduğu gibi, dirençli organizmaların, örneğin Pseudomonas türlerinin veya Candida türlerinin neden olduğu süperenfeksiyonlar meydana gelebilir. Piyeloseptil kullanımı ile sporadik Clostridium difficile süperenfeksiyonları veya psödomembranöz kolit raporları vardır.
Laboratuvar yan etkileri
Piyeloseptil kullanımı ile aşağıdaki laboratuvar yan etkileri bildirilmiştir; artmış AST (SGOT), artmış ALT (SGPT), azalmış hemoglobin, artmış serum fosforu, eozinofili, glukoz-6-fosfat dehidrojenaz eksikliği anemisi, agranülositoz, lökopeni, granülositopeni, hemolitik anemi, trombositopeni, megaloblastik kansızlık. Çoğu durumda, bu hematolojik anormallikler tedavinin kesilmesinden sonra çözülmüştür. Aplastik anemi nadiren bildirilmiştir.
Piyeloseptil hakkında bilmem gereken en önemli bilgiler nelerdir?
Piyeloseptyl kontrendikasyonları
Alerjiniz varsa veya ciddi böbrek hastalığınız, idrara çıkma problemleriniz veya Piyeloseptilin neden olduğu sarılık veya karaciğer problemleriniz varsa Piyeloseptil almamalısınız.
Hamileliğin son 2 ila 4 haftasındaysanız Piyeloseptil almayın.
Piyeloseptil almadan önce böbrek hastalığınız, kansızlığınız, şeker hastalığınız, elektrolit dengesizliğiniz veya B vitamini eksikliğiniz, genetik enzim eksikliğiniz veya herhangi bir zayıflatıcı hastalığınız varsa doktorunuza söyleyin.
Piyeloseptil’i yiyecekle birlikte alın.
Doktorunuzun tavsiyesi olmadan antasit kullanmaktan kaçının. Yalnızca doktorunuzun önerdiği antasit türünü kullanın. Bazı antasitler vücudunuzun Piyeloseptili emmesini zorlaştırabilir.
Bu ilacı öngörülen süre boyunca alınız. Enfeksiyon tamamen temizlenmeden belirtileriniz iyileşebilir. Piyeloseptil, soğuk algınlığı veya grip gibi viral bir enfeksiyonu tedavi etmeyecektir.
Ani göğüs ağrınız, kuru öksürüğünüz veya solunum problemleriniz varsa bu ilacı almayı bırakın ve hemen doktorunuzu arayın.
Sık sorulan sorular
Piyeloseptyl idrar söktürür mü?
Piyeloseptyl idrar söktürür. Mesanede ya da böbrekte bulunan bakterilerin temizlenmesi için kullanılır.
Piyeloseptyl reçetesiz verilir mi?
İlacı reçetesiz alabilirsiniz, ama doktor tavsiyesi olmadan kullanılması önerilmemektedir.
Piyeloseptyl antibiyotik mi?
Evet, peyiloseptyl antibiyotiktir.
Piyeloseptyl günde kaç defa içilir?
Günde dört kez 50-100 mg kullanılmaktadır.

TIBBİ SORUMLULUK REDDİ
Nkgoo, çeşitli tıbbi konular üzerine pek çok yazı içermektedir. Ancak, bu yazıların hatasız olduğunun hiçbir şekilde garantisi yoktur. Tıp ile ilgili bir bilgi hatasız bile olsa, sizin için ya da sizin rahatsızlığınızın belirtileri için uygulanabilir olmayabilir. Nkgoo.com sitesinde hiç bir bilgi doktor tavsiyesi yerine geçmez. Bu sebeple sitedeki tıbbi bilgilerin pratikte uygulanması halinde nkgoo.com sorumluluk kabul etmez ve herhangi bir yardımı taahhüt etmez. En doğru bilgiyi doktorunuza danışarak alabilirsiniz. Lütfen Yasal Uyarı Sayfamızı Okuyun.





